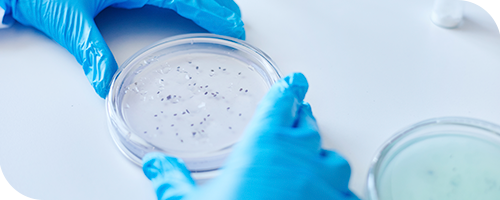

A Wana dispõe de tecnologia de dispersante com peso molecular controlado que atua efetivamente na dispersão de substâncias sólidas inorgânicas, como carbonato de cálcio, caulim, argilas, dióxido de titânio, entre outros.
A Wana dispõe de tecnologia de dispersante com peso molecular controlado que atua efetivamente na dispersão de substâncias sólidas inorgânicas, como carbonato de cálcio, caulim, argilas, dióxido de titânio, entre outros.


Modificador de reologia indicado para o espessamento e estabilização de formulações de limpadores multiuso, atuando como agente espessante conferindo altíssima viscosidade e suspensor de cargas minerais com excelente estabilidade.


Modificador de reologia que promove espessamento às formulações de lava-louças e lava-roupas líquido, com viscosidade adequada a cada situação, além da boa formação de espuma e aumentando significativamente o tempo de contato do produto com o substrato de aplicação, maximizando as reações envolvidas no processo de limpeza.
Promove transferência às formulações após neutralização com pH maior que 7, com excelente interação com cloreto de sódio e sulfato de magnésio.


Modificador de reologia que promove características de tixotropia às formulações, especialmente indicado para formulações onde a característica de gel seja desejável.

Modificador de reologia indicado para formulações de meio altamente alcalino, onde se é necessário altas viscosidade e transparência mesmo em pH maiores que 12.

Espessante acrílico que confere espessamento às formulações aquosas e alcoólicas, como por exemplo, sabonete líquido, shampoo e álcool em gel.

Base concentrada composta por mistura de tensoativos aniônicos, agentes espessantes, preservante e sequestrante.
Pode ser utilizado para fromulação de detergente lava-louças e de uso geral.
Tem como benefícios a diminuição do manuseio de produtos químicos perigosos, permitindo a preparação de formulações detergentes de forma simples, rápida e segura.

Modificador de reologia de médio espessamento, construtor de viscosidade KU e indicado para formulações que necessitam de um equilíbrio entre reologia e espessamento, com ótimas condições de fluidez.

Linha Modiwan de baixo a alto espessamento, para atender as mais diversas necessidades técnicas de aplicação, que oferecem um grande equilíbrio custo-benefício e uma reologia diferenciada junto a uma melhor eficiência de espessamento, atendendo as necessidades de diversos tipos de tintas e em diferentes níveis de PVC.

Modificador de reologia construtor de viscosidade KU de médio espessamento e alta fluidez, eficiente em tintas de médio e alto PVC, indicado para formulações que demandam reologia diferenciada, do que se diz respeito a fluidez e estabilidade, junto à redução dos respingos durante a aplicação mesmo em alto cisalhamento.

Linha Modiwan de baixo a alto espessamento, para atender as mais diversas necessidades técnicas de aplicação, que oferecem um grande equilíbrio custo-benefício e uma reologia diferenciada junto a uma melhor eficiência de espessamento, atendendo as necessidades de diversos tipos de tintas e em diferentes níveis de PVC.

Modificador de reologia construtor de viscosidade KU de médio a alto espessamento, que proporciona estabilidade das tintas, evitando separação de fases, sedimentação e sinérese.
Promove fluidez aos materiais, com um equilíbrio diferenciado nas questões de viscosidade, cisalhamento e reologia.

Linha Modiwan de baixo a alto espessamento, para atender as mais diversas necessidades técnicas de aplicação, que oferecem um grande equilíbrio custo-benefício e uma reologia diferenciada junto a uma melhor eficiência de espessamento, atendendo as necessidades de diversos tipos de tintas e em diferentes níveis de PVC.

Modificador reológico de médio a alto espessamento e excelente comportamento na curva reológica.

Modificador de reologia construtor de viscosidade KU de médio a alto espessamento, com características de reologia tixotrópica. Possui espessamento que proporciona excelente relação entre viscosidade e reatividade.

Linha Modiwan de baixo a alto espessamento, para atender as mais diversas necessidades técnicas de aplicação, que oferecem um grande equilíbrio custo-benefício e uma reologia diferenciada junto a uma melhor eficiência de espessamento, atendendo as necessidades de diversos tipos de tintas e em diferentes níveis de PVC.

Modificador reológico de excelente equilíbrio na taxa de deformação reológica e retenção de água.

Emulsão aquosa de copolímero acrílico utilizada como agente opacificante em formulações desinfetantes.
Possui excelente compatibilidade com tensoativos catiônicos, além de poder ser utilizado junto a diferentes tipos de fragrâncias e classes de corantes.

Emulsão aquosa de copolímero acrílico utilizada como agente opacificante em formulações de detergentes lava-louças e desinfetantes.
Possui excelente compatibilidade com tensoativos catiônicos, além de poder ser utilizado junto a diferentes tipos de fragrâncias e classes de corantes.


Poliacrilato de sódio, atua como agente anti-redepositante em formulações de lava-roupas líquido.


Copolímero acrílico maleico, atua como agente antiredepositante em formulações de lava-roupas líquido e detergente em pó, prevenindo a redeposição de sujeira, aumentando a efetividade de limpeza dos tensoativos.





Resina metalizada indicada para uso em ceras semi-polimentáveis, alto brilho e polidores, essas de alta performance com habilidade de manter o alto brilho do filme em longo tempo de tráfego.

Resina álcali solúvel.

Espessante sintético não iônico, indicado para formulações de sanenates, promovendo o espessamento de detergentes líquidos.
Confere maior estabilidade física, mantendo a transparência dos materiais sob condições de baixa temperatura e evitando separação de fases.
Atua como alterativa às amidas sintéticas e espessantes celulósicos comumente utilizados para o mesmo fim, agindo em sinergia com eletrólitos.

Co-ligante que proporciona melhor formação de filme e atua como carrier de alvejante nas formulações de tinta para revestimento.

Co-ligante que proporciona melhor formação de filme e atua como carrier de alvejante nas formulações de tinta para revestimento.


Agente preservante a base de benzisotiazolinona, possui estabilidade em sistemas com temperatura acima de 60°C, atendendo a regulamentação da ANVISA para conservantes de produtos saneantes.
Indicado para sistemas fortemente alcalinos.


Mistura de isotiazolinonas e halogenados
BENEFÍCIOS
*Os valores e os resultados obtidos podem variar de acordo com a formulação escolhido.

Sanitizante a base de DBNPA, isento de formaldeído, efeito com fast kill nas sanitizações com controle de sanitização em equipamentos, tubulações e unidades fabris.

Adesivo utilizado em berços e mesas de estamparia localizada.

Látex acrílico de média viscosidade, proporciona melhor qualidade de impressão, além do ganho de performance na secagem. Indicado para revestimento de papel couché, especiais e cartão.

Látex acrílico ideal para processos de laminação e colagem de papéis, com ótimas performance em hidrorrepelência.

Antiespumante emulsionado livre de silicone. Excelente desempenho em controle de espuma na caixa de entrada, podendo ser usado em formulações de tintas couché.o.

Antiespumante em emulsão de base siliconada, possui ação desaerante, antiespumante e previne a formação de espuma.
Indicado para a utilização em processos gerais que necessitem de ações anti espumas e bolhas.

Poliacrilato de sódio, produto que oferece melhor estabilidade e performance para dispersão de cargas minerais e tintas de revestimento.

Poliacrilato de sódio destinado para uso em tinta de revestimento que visa custo-benefício.

Poliacrilato de sódio desenvolvido para sistemas de tinta couché que possuem alto teor de sólidos e alta viscosidade de aplicação.

Agente complexante obtido através da mistura de sal tetrassódico do ácido etilenodiaminotetracético e do ácido 1-hidroxietano-1,1-difosfônico.
Possui excelente poder complexante de ínos metálicos, formando quelatos solúveis e inertes, podendo ser utilizado em formulações de sabões e sabonetes.

Agente quelante biodegradável e de fonte renovável, obtido através da oxidação da glucose.
Proporciona excelente ação sequestrante em ampla faixa de pH, podendo ser utilizado em soluções alcalinas e alcalinas concentradas, formando quelatos estáveis com cálcio, ferro, cobre, alumínio e outro metais pesados.

Agente complexante na forma aquosa a 40% de sal tetrasódico do ácido etilenodiamino tetracético. Em sua forma econômica em comparação ao EDTA, recomendado para aplicações industriais em fromulações como lava-louças, lava-roupas líquido, shampoo e sabonete líquido.

Atua como alternativa ao Tripolifosfato de Sódio nas mais diversas aplicações, que apresenta boa ação sequestrante em ampla faixa de pH, inclusive em meios extremamente alcalinos.
Atua ainda como agente anti-redepositante, mantendo assim a superfície limpa por mais tempo, não interferindo nas propriedades espumantes das formulações.

Dispersante polimérico neutralizado com ação efetiva para evitar redeposição de corantes não fixados nas fibras em processos de lavação posteriores.

Dispersante de baixo peso molecular para cargas com excelente desempenho na estabilidade da dispersão.

Antiespumante base óleo versátil para uso em processo têxtil.

Ligante acrílico rígido para consolidação TNT de alto desempenho em equipamentos de baixa temperatura.

Ligante acrílico rígido para acabamentos têxteis, desenvolvido para uso em processos com eficiência de temperatura.

Ligante acrílico macio para consolidação TNT de alto desempenho em equipamentos de baixa temperatura.

Ligante acrílico macio com cura em estufa de alto teor de sólidos, que proporciona excelente rendimento de cor e alto desempenho em equipamentos de baixa temperatura.

Ligante acrílico macio com cura em estufa com excelente rendimento de cor e alto desempenho em equipamentos de baixa temperatura.

Ligante acrílico macio de cura ao ar com excelente rendimento de cor e equilíbrio ativo no desenvolvimento de viscosidade.

Umectante de alta performance com capacidade de reduzir a tensão superficial, junto a elevada umectação das partículas.

Espessante acrílico para uso em combinação com espessante tipo emulsão inversa, para melhora
da definição de filetes e imagens no processo de estamparia.
Se você deseja conhecer mais sobre nosso portfólio e entender qual solução é ideal para o seu processo, nossa equipe está pronta para ajudar.
Clique nas opções de contato abaixo e fale com um dos nossos especialistas.
Vamos construir juntos a melhor solução para o seu negócio!